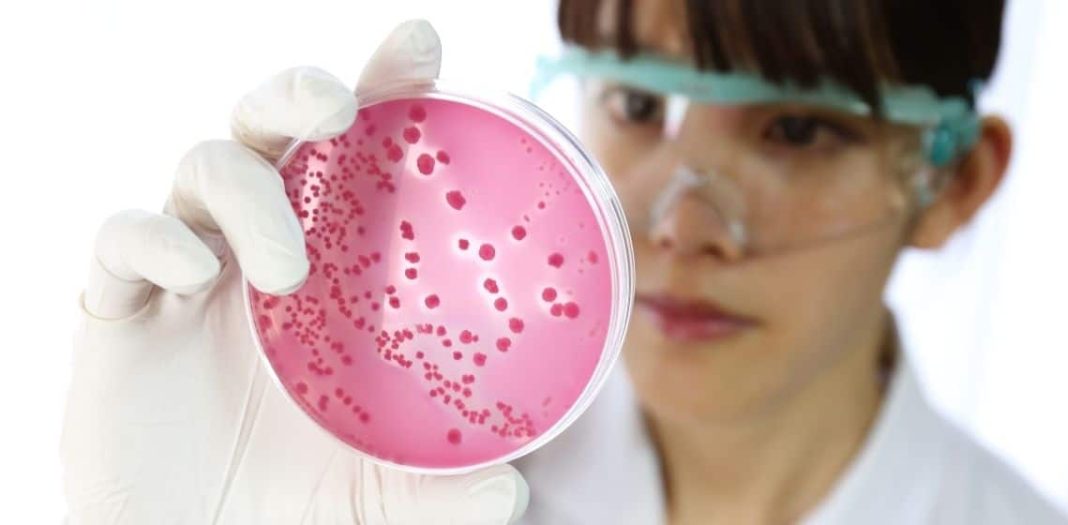
Urispas Nedir, Ne İçin Kullanılır?

Flavoksat, özellikle idrar yolu rahatsızlıklarının tedavisinde kullanılan bir ilaçtır. İdrar yolları üzerindeki kasları gevşeterek, idrar yapma sırasındaki ağrıyı, sıkışmayı ve sık idrara çıkma gibi semptomları hafifletmek amacıyla reçete edilir. Ayrıca interstisyel sistit gibi kronik durumların yönetiminde de yardımcı olabilir. İlaç, genellikle idrar yolu enfeksiyonları, taşlar veya cerrahi müdahaleler sonrası ortaya çıkan spazmları kontrol altına almak için kullanılır.
İçerikler:
ToggleFlavoksat Nasıl Kullanılır ve Dozaj Bilgileri
Flavoksat, doktorun önerdiği dozaj ve süre boyunca alınmalıdır. Tipik olarak, yetişkinler için önerilen doz günde üç veya dört kez alınan 100-200 mg tabletler şeklindedir. İlacın alımı genellikle yemeklerle birlikte veya yemeklerden hemen sonra yapılır çünkü bu, mide rahatsızlığını önlemeye yardımcı olabilir. Tedavi süresince yeterli miktarda su tüketmek, ilacın etkinliğini artırabilir ve yan etkileri azaltabilir.
Flavoksatın Yan Etkileri ve Önlemler
Flavoksat kullanımının bazı yaygın yan etkileri arasında bulantı, kusma, baş dönmesi ve ağız kuruluğu bulunur. Daha ciddi yan etkiler, örneğin göz ağrısı, görme bulanıklığı ve idrar yaparken zorlanma gibi durumlar nadiren ortaya çıkabilir. Bu tür semptomlar yaşandığında hemen doktor bilgilendirilmelidir.
Flavoksat başka ilaçlarla etkileşime girebilir, bu nedenle eğer reçeteli veya reçetesiz başka ilaçlar kullanılıyorsa doktora bildirilmelidir. Özellikle diğer kas gevşeticilerle birlikte kullanıldığında etkileşimler meydana gelebilir. Flavoksat kullanımı sırasında alkol tüketimi bazı yan etkileri artırabilir, bu yüzden alkol alımı kısıtlanmalı veya tamamen kesilmelidir.
Dikkat Edilmesi Gerekenler ve Tedavi Süreci
Flavoksat alırken dikkat edilmesi gereken önemli bir nokta, ilacın doğru kullanımıdır. İlacı asla önerilenden daha fazla veya daha az almayın ve tedavi süresince düzenli doktor kontrollerinizi ihmal etmeyin. İlacı aniden bırakmak bazı durumlarda semptomların şiddetlenmesine neden olabilir, bu nedenle dozajın düşürülmesi veya ilacın kesilmesi konusunda doktorunuzun yönlendirmesine ihtiyacınız olacaktır.
Flavoksat kullanımı sırasında herhangi bir sağlık değişikliği fark ederseniz, özellikle idrarda renk değişikliği veya idrar yapma alışkanlıklarında anormallikler gibi, bu durumlar acil tıbbi müdahale gerektirebilir. Böyle bir durumda, en kısa sürede sağlık kuruluşuna başvurun.